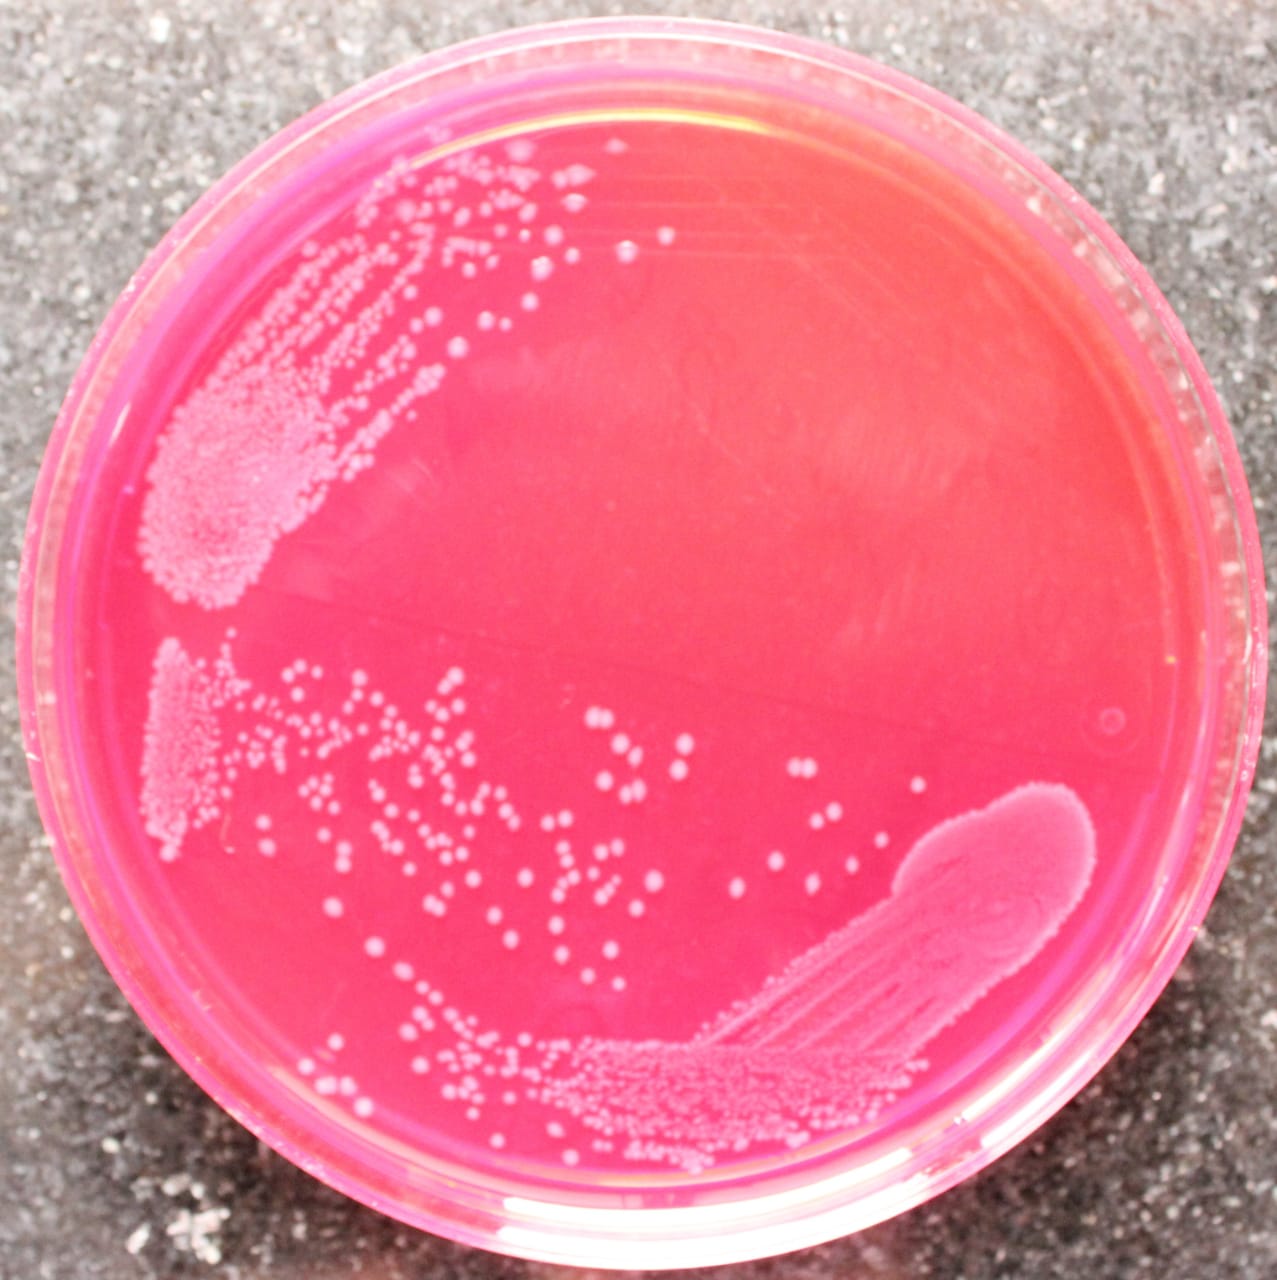

vi. Always mention the UN category number of infectious substances.
vii. Any researchers across India can deposit strains at the NRAMRB laboratory, ICMR-NIRBI via filling up online form “online culture deposition”(see Annexure IV).
viii. The packaging should include proper sender details i.e., Name, Designation, Department, Institute name, address, Fax, Email including emergency contact number.
Shipment of Isolates:
i. Communicate with the courier company regarding the type of the shipment particularly the biological hazard nature.
ii. Before sending the isolates to the NRAMRB Laboratory, the sender always communicates before-hand and provide the courier/shipment details including tracking number.
iii. Avoid shipping when the transit falls on weekends and public holidays to minimise shipment time and/or delay in receiving.
Contact details
Laboratory-in-charge
National Repository of Antimicrobial Resistant Bacteria (NRAMRB),
ICMR - National Institute for Research in Bacterial Infections (NIRBI)
(formerly ICMR - National Institute of Cholera and Enteric Diseases (NICED)),
NICED-I Building (adjacent to Subhas Sarobar),
P-33, C.I.T. Road, Scheme XM, Beliaghata,
West Bengal, Kolkata 700010
email ID: nramrb2021@gmail.com
Telephone: Mobile: 91-8981527805; P:+91-(0)33-23705533/4478 (Extn.1212)